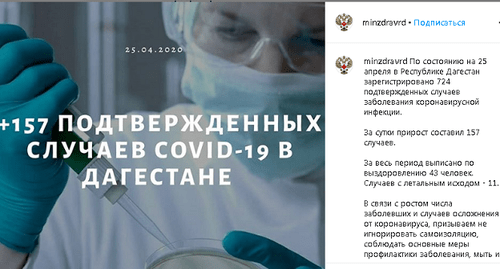
Скриншот страницы Минздрава Дагестана в Instagram https://www.instagram.com/p/B_ZtV5eF9p8/

Число зараженных в Дагестане достигло 724
НАСТОЯЩИЙ МАТЕРИАЛ (ИНФОРМАЦИЯ) ПРОИЗВЕДЕН И РАСПРОСТРАНЕН ИНОСТРАННЫМ АГЕНТОМ ООО "МЕМО", ЛИБО КАСАЕТСЯ ДЕЯТЕЛЬНОСТИ ИНОСТРАННОГО АГЕНТА ООО "МЕМО".
157 случаев заражения коронавирусом зарегистрированы в Дагестане за сутки, и общее число заболевших составило 724.
Как писал "Кавказский узел", среди регионов СКФО по числу зараженных коронавирусом на 24 апреля вновь лидировал Дагестан, где за сутки были выявлены 113 зараженных, а общее их число за период эпидемии составило 567 человек. Число выздоровевших к тому времени было 43, а умерших - 11.
"По состоянию на 25 апреля в Республике Дагестан зарегистрировано 724 подтвержденных случая заболевания коронавирусной инфекцией. За сутки прирост составил 157 случаев. За весь период выписаны по выздоровлению 43 человека. Случаев с летальным исходом - 11", - сказано в сообщении на странице Минздрава Дагестана в Instagram.
Ведомство призвало жителей республики не нарушать режим самоизоляции и "соблюдать основные меры профилактики заболевания".
С 1 апреля в Дагестане объявлен режим самоизоляции. С 19 апреля на въездах в города и районы республики установлены блокпосты, говорится в справке "Кавказского узла" "Коронавирус добрался до Кавказа". Информация о штрафах за нарушение карантина собрана в публикации "Кавказского узла" "Сколько стоит побег из карантина".
Советы специалистов о том, как избежать заражения, приведены в справке "Кавказского узла" "Врачи про коронавирус: что делать?", а номера телефонов для консультаций по коронавирусу - в справке "Коронавирус. Горячие линии".
Материалы о распространении коронавируса на юге России и в странах Южного Кавказа размещаются "Кавказским узлом" на тематической странице "Коронавирус рвется на Кавказ". На главной странице "Кавказского узла" шесть раз в сутки обновляется карта с указанием числа заболевших коронавирусом в регионах юга России и странах Южного Кавказа. Карта содержит данные Роспотребнадзора, Минздрава России и университета Джонса Хопкинса.
Мы обновили приложения на Android и IOS! Будем признательны за критику, идеи по развитию как в Google Play/App Store, так и на страницах КУ в соцсетях. Без установки VPN вы можете читать нас в Telegram (в Дагестане, Чечне и Ингушетии – с VPN). Через VPN можно продолжать читать "Кавказский узел" на сайте, как обычно, и в соцсетях Facebook*, Instagram*, "ВКонтакте", "Одноклассники" и X. Смотреть видео "Кавказского узла" можно в YouTube. Присылайте в WhatsApp* сообщения на номер +49 157 72317856, в Telegram – на тот же номер или пишите по адресу @Caucasian_Knot.
* деятельность компании Meta (владеет Facebook, Instagram и WhatsApp) запрещена в России.

![У мемориала «Исход и Возвращение» в Элисте 28 декабря 2019 года. Фото: пресс-служба главы Калмыкии. http://glava.region08.ru/ru/soobscheniya-dlya-pressy/12990-pr.html#!prettyPhoto[gallerydbde2adecd]/4/ У мемориала «Исход и Возвращение» в Элисте 28 декабря 2019 года. Фото: пресс-служба главы Калмыкии. http://glava.region08.ru/ru/soobscheniya-dlya-pressy/12990-pr.html#!prettyPhoto[gallerydbde2adecd]/4/](/system/uploads/article_image/image/0026/267478/main_image_preview_DSC_9386_1.jpg)







